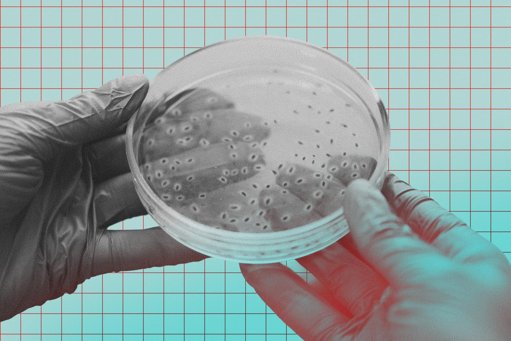
News Image

Rougeurs, démangeaisons… lorsqu’un médicament censé soulager devient source d’inconfort, la question se pose : que faire si mon corps ne le supporte pas ? L’hypersensibilité médicamenteuse n’est pas rare, mais elle reste souvent mal comprise et source d’inquiétude. On fait le point avec des experts.